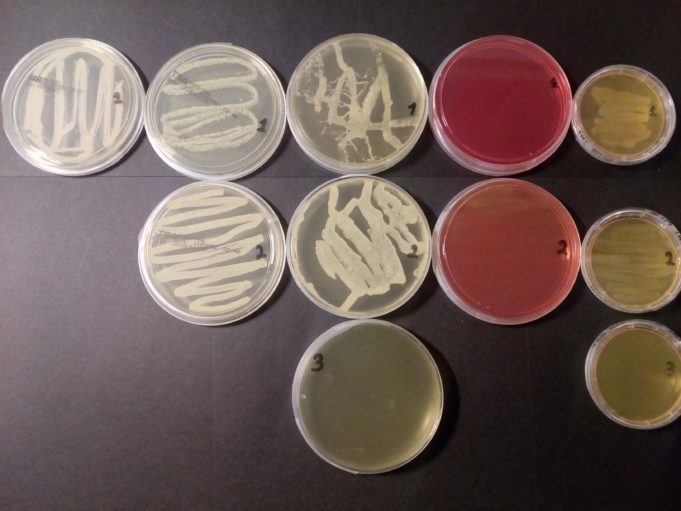

Ως "Μαραθώνιος Δρόμος" ορίζεται το αγώνισμα δρόμου μεγάλης αποστάσεως (42.195 χλμ.), που περιλαμβάνεται στο πρόγραμμα των Ολυμπιακών Αγώνων από την πρώτη διοργάνωση το 1896 στην Αθήνα. Μαζί με τα 100 μ. είναι τα δύο πιο δημοφιλή αγωνίσματα του στίβου.
Στην...
Πέμπτη 08 Μαρτίου, και όπως κάθε Πέμπτη η ραδιοφωνική παρέα, χορηγούμενη από το Φροντιστήριο "Κυρίτσης" μάς κρατά μια ώρα συντροφιά με θέματα Παιδείας.
Αυτή τη φορά το επίκεντρο είναι η Φυσική μας Αγωγή, η άθληση και η διατροφή μας. 'Ολοι...
Το Πανεπιστήμιο Κύπρου είναι Νομικό Πρόσωπο Δημοσίου Δικαίου και διοικείται από το Συμβούλιο, το οποίο «έχει τη διαχείριση και έλεγχο των διοικητικών και οικονομικών υποθέσεων του Πανεπιστημίου και της περιουσίας του», και τη Σύγκλητο, η οποία «αποτελεί το ανώτατο...
Η βαρύτητα του θέματος "Επαγγελματικός Προσανατολισμός" είναι μεγάλη για την εκπαιδευτική ομάδα του "Φροντιστηρίου Κυρίτσης". Συνεπώς και το ενδιαφέρον μας ακόμα μεγαλύτερο, τόσο που το θέμα δεν χώρεσε σε μια μόνο "Ώρα της Παιδείας".
Δεύτερο μέρος λοιπόν, για ένα θέμα...
Εκδόθηκε στις 05/03/2018, η υπουργική απόφαση σχετικά με τη μετεγγραφή αδελφών, προπτυχιακών φοιτητών ΑΕΙ, που σπουδάζουν σε διαφορετική Περιφερειακή Ενότητα τόσο μεταξύ τους όσο και από αυτήν όπου διαμένουν οι γονείς τους.
Η απόφαση ορίζει ότι μόνο οι φοιτητές των...
Στο πλαίσιο της προσπάθειας μας να είμαστε δίπλα στους μαθητές μας κάνοντας τους να κατανοούν το μάθημα όσο το δυνατόν περισσότερο, διοργανώνουμε συχνά πειράματα Χημείας ή Βιολογίας Λυκείου. Με τον τρόπο αυτό οι μαθητές βλέπουν σε πραγματικό χρόνο πώς...
Στις 6 Ιουνίου 2018 θα αρχίσουν οι φετινές Πανελλήνιες εξετάσεις στα Γενικά Λύκεια για την εισαγωγή των υποψηφίων στα ανώτατα ιδρύματα της χώρας.
Στα επαγγελματικά Λύκεια θα ξεκινήσουν μία ημέρα μετά στις 7 του ίδιου μήνα. Οι ημερομηνίες αναμένεται να...
Μια όμορφη ανοιξιάτικη Κυριακή, την 04/03/2018, επέλεξε το "Φροντιστήριο Κυρίτσης" να διοργανώσει μια ημέρα σταδιοδρομίας με πρωταγωνιστές τους μαθητές του Λυκείου, στο κέντρο της Αθήνας.
Το φροντιστήριο μας σε συνεργασία με την εταιρεία συμβούλων επαγγελματικού προσανατολισμού " Orientum" , πραγματοποίησαν...
Ο Λυσί@ς είναι Πανελλήνιος Μαθητικός Διαγωνισμός μέσω Internet, ο οποίος οργανώνεται για 22η συνεχή χρονιά.
Ο διαγωνισμός διεξάγεται, παραδοσιακά υπό την αιγίδα του Υπουργείου Παιδείας, Έρευνας και Θρησκευμάτων, από τα Εκπαιδευτήρια Δούκα, και την COSMOTE, με χρυσό χορηγό τη Microsoft Hellas, και τη συνεργασία του Ιδρύματος Λαμπράκη, της ΕΕΔΕ, της ΕΠΥ και της Cyprus Computer Society, διακεκριμένων επιστημόνων από Εκπαιδευτικά...